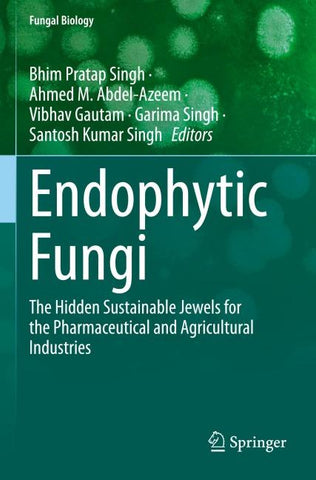
Endophytic Fungi

Weitere Formate
Autorenfreundlich Bücher kaufen?!

Beschreibung
Excessive use of pesticides in agriculture as well as in the food supply chain have led to increased antimicrobial resistance (AMR), which is one of the more serious global health concerns. Endophytic fungi and their associated bioactive substances have been reported to show natural ability to fight against pathogens and can reduce the development of AMR in nature. Studies also reported their potential as producers of hormones that enhance plant growth and several compounds having biological activities without any adverse effects.
This book covers the pharmaceutical potential offungal endophytes as elucidated through advanced bioinformatics tools and modern techniques. Also synthetic drugs are losing their efficacy to treat microbial-induced disease due to this emergence of drug-resistant microbes. Therefore, insight into the detection of valuable plant constituents is a pressing priority in order to achieve effective pharmaceutical treatments. This book provides lucid discussion of the most recent research and provides knowledge about the applications of endophytic fungi with a specific focus to their pharmaceutical potential.
The Hidden Sustainable Jewels for the Pharmaceutical and Agricultural Industries
The Hidden Sustainable Jewels for the Pharmaceutical and Agricultural Industries
Details
| Verlag | Springer International Publishing |
| Ersterscheinung | 27. Januar 2025 |
| Maße | 23.5 cm x 15.5 cm |
| Gewicht | 569 Gramm |
| Format | Softcover |
| ISBN-13 | 9783031491146 |
| Seiten | 348 |